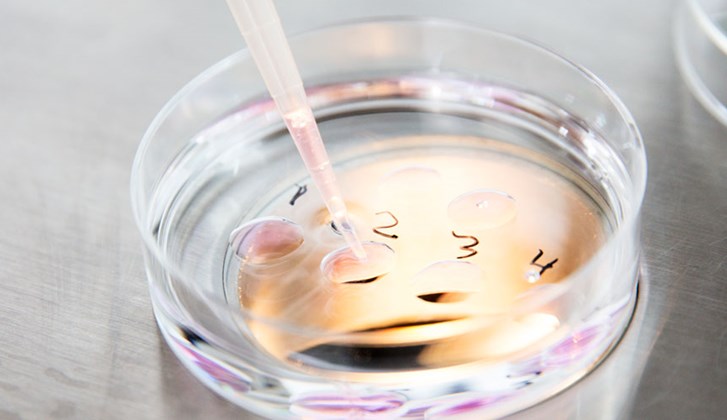
What is the difference between IVF treatment and insemination?

Fertility Advice & News | Vitanova
09.07.25
Women want a gentler treatment with fewer physical and emotional burdens “I don’t want to feel my body is out of control. I’m not sure how I could cope with mood swings or daily injections!” In conventional IVF drugs are given in the form of daily injections (or occasionally in the form of nasal...
19.02.24
When it comes to fertility treatment, couples often find themselves exploring options beyond their home country. Denmark has emerged as a popular destination for individuals seeking IVF and other fertility treatments. The Vitanova clinic, based in Copenhagen provides a range of quality fertility...
28.07.23
Each year, around 600 Danish women need donor eggs. Some women may have undergone an early menopause or had their ovaries removed because of illness. Other women have serious genetic disorders that they do not want to pass on to their children. With egg donation, a woman donates some of her unfer...
19.05.21
Here we have long pioneered and practised Natural and Mild IVF as a safer alternative to conventional IVF treatment. Our approach combines success rates that are equal to or better than the national average for IVF, while being gentler on women’s bodies, with better health outcomes Conventional...
19.05.21
Working with your body, not against it. Why natural and mild IVF is better for women, mothers and babies Frustration– because you’re finding it hard to get clear information on why you are struggling to fall pregnant, or time is ticking away as you wait for your next appointment. Anxiety– becau...
19.05.21
How are Mild and Natural IVF different from conventional IVF? Mild and Natural IVF are different from conventional IVF in their approach. Whilst Mild and Natural IVF focus on the quality of eggs retrieved and work alongside the woman’s natural menstrual cycle, conventional IVF uses stimulating d...
18.05.21
In the field of fertility, we understand that there are a lot of terms, acronyms and abbreviations to keep track of and understand. So, we’ve created our own fertility glossary so that you’re in the know from the get-go when it comes to your fertility journey: Understanding hormones AMH: stands...
18.05.21
What is Natural IVF? Natural IVF refers to IVF which uses fewer drugs than conventional IVF, and works within a woman’s own natural cycle. Conventional IVF uses drugs to shut the menstrual cycle down (‘down-regulation’) before re-starting it again, and then uses stimulating drugs to grow follicl...
18.05.21
1. Infertility is not uncommon Unfortunately, infertility is not as unusual today as it used to be. Statistically, infertility affects one in six couples and is caused by problems with the woman in 40% of cases, problems with the man in 40% of cases, and problems with both parties in 20% of case...
18.05.21
Assisted fertilisation or ART (assisted reproductive technology) used to be known as artificial insemination. We prefer the notion that we assist with fertilisation, so this is the term we normally use. More information on the methods used in assisted fertilisation is provided here. IUI – intrau...
27.01.21
Poor sperm quality could mean that up to 15% of men will find it difficult to make their partners pregnant without fertility treatment, and that 25% may have to wait a fairly long time before pregnancy becomes a reality.A lot of advice is available on how men can improve the quality of their spe...
27.01.21
Women who have passed the age of 35 and have not yet had children often feel that they are under time pressure if they are going to have children and are very concerned about their fertility. But it is important to understand that fertility does not decrease abruptly but that it occurs as a smoo...
27.01.21
Failing to conceive can be stressful, but could stress and worry affect your chances of conceiving?Many studies have been conducted in order to find out whether stress can affect fertility, but there their findings have been limited.However, it is generally believed that very high stress levels...
27.01.21
Conception takes place about two weeks before the anticipated first day of your period, so few women are aware that they are pregnant until at least 2-3 weeks later. The foetus is most vulnerable to harmful effects early on in pregnancy, during weeks 3-8, while the organs are being formed.It is...
27.01.21
It is particularly important to eat a healthy and varied diet when pregnant. Anything missing from your diet could affect your baby’s development. Pregnancy therefore gives you a great opportunity to review your eating habits and consider whether there are any types of food that are missing from...
27.01.21
IVF / TEST TUBE TREATMENT Test tube treatment is often abbreviated as IVF, which stands for In Vitro Fertilization and means that fertilization takes place outside the woman's body in a glass. During IVF treatment, the egg is removed from the ovaries to be fertilized with the semen in a laborato...
27.01.21
There are various forms of donation: anonymous, identified and known donors. This article describes the differences between the various forms. With anonymous egg or sperm donation, the only information available to the woman/couple relates to the skin colour, hair colour, eye colour, height, wei...
27.01.21
Sexually transmitted diseases should be prevented by avoiding unprotected sex, and any existing sexually transmitted disease should be treated. Infections caused by sexually transmitted diseases may result in infertility in both men and women. Being overweight or underweight may reduce your cha...
27.01.21
The woman is most likely to become pregnant on the day of ovulation or the day before. Using an ovulation test is an easy and safe way to predict ovulation and thus the fertile period, which lasts 5-7 days. The ovulation test measures the concentration of the ovulation hormone LH hormone (lutein...
27.01.21
Many men may find it awkward to have to provide a sperm sample on demand at a clinic, or feel that this goes beyond their boundaries. Therefore, many men may be pleased to know that it is now possible to perform a test at home. Danish specialists have developed a home test that can give an indica...
27.01.21
Endometriosis is a chronic disease that can be found in 4-7% of all women. Cells similar to the mucosa of the uterus (endometrium) are found outside the uterus, primarily on the ovaries, fallopian tubes, the outside of the uterus and the abdominal cavity. These cells behave just like the cells in...
27.01.21
If you are pregnant or want to get pregnant, it is important to lead a healthy lifestyle - both for you and your child. At Vitanova we have put together a number of tips for creating good habits in your life, both before, during and after your pregnancy. Motion Good fitness as well as strong mu...
27.01.21
There can be many reasons why a woman cannot become pregnant within the first years of trying. In this article we describe the most frequent causes of infertility among women. The most frequent causes of infertility in women are: Enclosed fallopian tubes Irregular or lack of ovulation Age Very...
26.11.20
What is Acupuncture? Acupuncture can be given before insemination or IVF or immediately after. The acupuncturist inserts needles while you lie on the couch. You relax for about 25 minutes and the acupuncturist removes most of the needles. After insemination or ovum pick-up the acupuncturist inse...
26.11.20
Infertility or involuntary childlessness is due to the man’s and/or the woman’s lack of ability of ensures pregnancy by regular sexual intercourse. According to the present state of science, a couple who have actively tried in vain to become pregnant for at least a year are considered to be infer...
26.11.20
During the initial conversation prior to insemination or IVF treatment we will among other things discuss lifestyle and fertility with you. Fertility can be measured from the time elapsed from the decision to become pregnant until successful pregnancy. This period varies from couple to couple, ge...